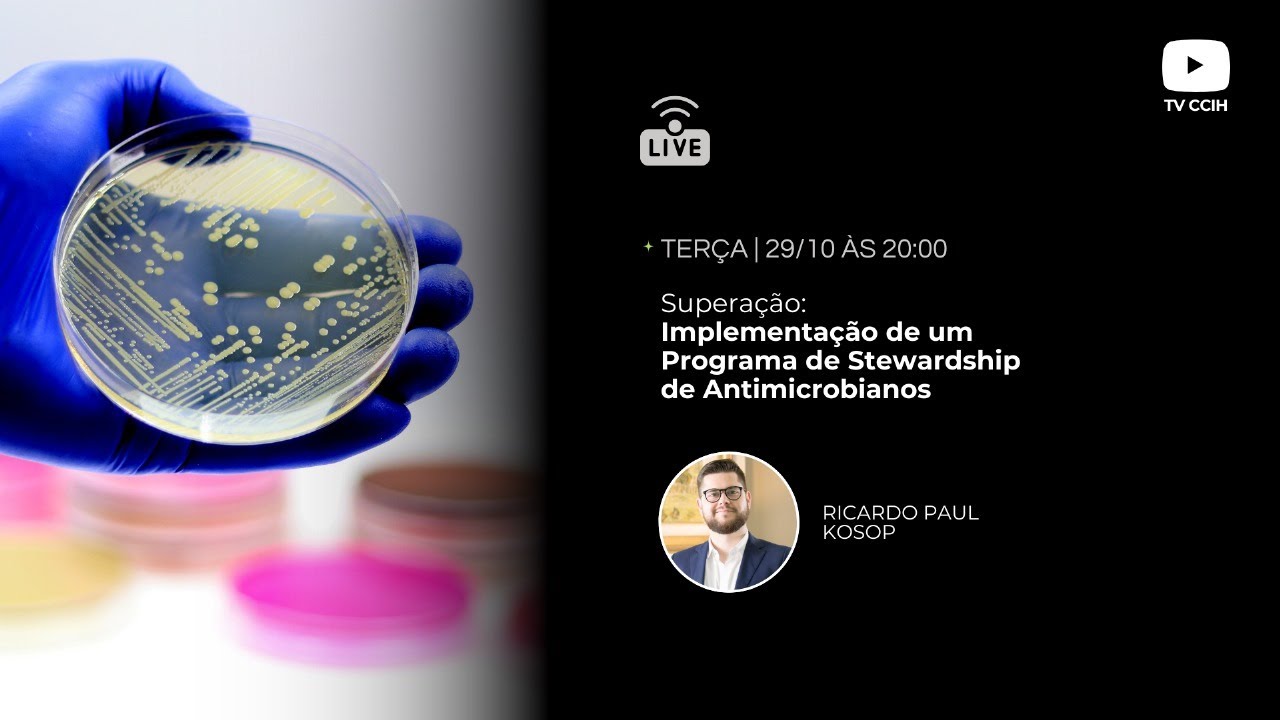
Ricardo Paul Kosop-10

Av. João Gualberto, 1342 - sala 1813 - Alto da Glória, Curitiba 80030001
Retomando os atendimentos presenciais em consultório e por Telemedicina a partir de Agosto/2025!
Ler mais11/08/2025
Curitiba 2 endereços
Número de registro: CRM PR 28565 RQE Nº: 19142
295 opiniões

Av. João Gualberto, 1342 - sala 1813 - Alto da Glória, Curitiba 80030001
Retomando os atendimentos presenciais em consultório e por Telemedicina a partir de Agosto/2025!
Ler mais11/08/2025
Este especialista não oferece agendamento online neste endereço
Este especialista só aceita pacientes particulares. Você pode pagar particular para marcar, ou encontrar outro especialista que aceite o seu plano de saúde.
295 opiniões
Profissional muito atencioso, de fácil entendimento.
Dr. Ricardo Paul Kosop
Olá Denise, que bom que consegui lhe deixar bem informada e sem dúvidas quanto ao seu diagnóstico e plano de tratamento! Conte comigo neste processo!
Ótimo médico, atencioso e empático. Explicou todos os passos do tratamento com calma. Recomendo!
Dr. Ricardo Paul Kosop
Olá MW! Que bom que conseguimos traçar um caminho juntos rumo à sua recuperação. Conte comigo!
Excelente profissional, atualizado. Vale o investimento na consulta.
Dr. Ricardo Paul Kosop
Agradeço as palavras, Giorgio! Conte comigo e até breve!
O Dr. Kosop é um profissional extremamente competente e dedicado. Atua com atenção aos detalhes durante a consulta, e é sempre muito claro sobre cada aspecto do atendimento.
Dr. Ricardo Paul Kosop
Obrigado pela confiança, T.S.! Que bom que sentiu-se acolhido!
Muito atencioso, cuidadoso e informado. Explica os detalhes e deixa o paciente seguro.
Dr. Ricardo Paul Kosop
Olá Pedro! Agradeço a confiança! Fico feliz que se sentiu acolhido, minha principal preocupação é sempre conseguir deixar o paciente seguro e confiante quanto ao seu diagnóstico e tratamento com empatia e dedicação. Conte comigo!
Ahhh, o Dr. Ricardo é maravilhoso!!!!
Excelente profissional, sabe ouvir, entender o problema e tratar pela raiz.
Cheguei ao consultório meio sem rumo, com o andamento do tratamento, as coisas mudaram e para melhor :)
O Dr. Ricardo sabe curar a dor!!!
Recomendo, falo bem, indico, falo que o café da recepção é bom demais, amo conversar com a secretária. O consultório é acolhedor.
Tudibaummmmm :)
Dr. Ricardo Paul Kosop
Agradeço de coração o carinho, Rômulo! Conte sempre comigo! Grande abraço!
Excelente profissional, muito atencioso, um excelente investigador!
Me passou muita confiança .
Dr. Ricardo Paul Kosop
Que bom que se sentiu acolhida! Conte comigo para fecharmos seu diagnóstico de forma segura e assertiva!
Já havia consultado presencialmente e por teleconsulta foi tão bom quanto. Atendimento sem pressa, explicou 200% do necessário, super paciente com minha ansiedade pelos resultados.
Sensacional
Dr. Ricardo Paul Kosop
Olá M.R.! Agradeço suas palavras e fico contente em saber que pude te acolher e, assim, cuidarmos do seu caso com a prioridade que você necessitava sem que isso piorasse a sua ansiedade (pelo contrário, conseguimos amenizar com uma boa "dose de médico")! Conte comigo sempre que precisar. Fique bem!
Excelente atendimento. Pontual. Atencioso e preciso em resolver os problemas.
Dr. Ricardo Paul Kosop
Obrigado pela confiança, Luciano! Conte comigo!
Infelizmente o Dr está saindo e não poderei mais continuar o tratamento com ele
Dr. Ricardo Paul Kosop
Olá Mariliei, como vai?
Agradeço o carinho e oportunidade de poder cuidar de você!
Infelizmente tive que suspender meus atendimentos neste período de Julho/2024 a Julho/2025 enquanto me dedicava à implementação de um grande projeto de Uso Racional de Antimicrobianos (Stewardship de Antimicrobianos) no ambiente hospitalar! Mas gostaria de aproveitar meu agradecimento à você e divulgar que retornei aos atendimentos em consultório e minha agenda encontra-se reaberta desde Agosto/2025! Caso necessite novamente não hesite em retornar!
104 dúvidas de pacientes respondidas na Doctoralia
Olá.
Faço uso da PreP diariamente, sempre as 23h.
Porém no dia de ontem eu me esqueci de tomar o medicamento, tomei assim que lembrei as 3h da manhã, ou seja, aproximadamente 4 horas depois.
Existe neste caso algum comprometimento com a eficácia da PreP?
Olá! Como vai? Como você faz uso regular e diário da PrEP de forma consistente, este pequeno "escorregão" na sua rotina da tomada da medicação não vai afetar a eficácia da PrEP para você!
Tenho uma vida sexual bastante ativa ao ponto de ter relações sexuais praticamente todos os dias com vários HSH desconhecidos (sem proteção mas em uso da PrEP diária com rigorosidade). Faço exames de ISTs todos os meses (1x/mês). É exagero ?
Olá! Como vai? Espero que você esteja bem! Creio que a frequência de exames para ISTs está bem condizente com sua exposição atual! O uso da PrEP é fundamental, continue utilizando-a diariamente! O ideal seria que você também acrescentasse o uso do preservativo nas suas relações, pois infelizmente existem outras ISTs que a PrEP não protege (em especial gonorreia, clamídia, sífilis e hepatite C). Seria muito importante que você também seguisse regularmente com um médico infectologista para lhe acompanhar e individualizar as melhores estratégias de prevenção, diagnóstico precoce e tratamento direcionado na eventualidade de você desenvolver quaisquer ISTs. Além da PrEP e do preservativo, no guarda-chuvas de cuidado sempre incluímos uma revisão extensa de vacinação (como para HPV e hepatite B), DoxyPEP, testagem específica para algumas ISTs (como paineis moleculares para clamídia e gonococo), entre outras, devem fazer parte do seu cuidado. Também importante avaliar seu histórico de uso/abuso de substâncias, pois práticas como "ChemSex" aumentam muito a vulnerabilidade não só a ISTs como a outras situações de risco que devem ser endereçadas e acolhidas com seu devido cuidado e valor. Espero que isso possa lhe ajudar a te dar um norte, mas não se esqueça: cuidado nunca é demais!
Todos os conteúdos publicados no doctoralia.com.br, principalmente perguntas e respostas na área da medicina, têm caráter meramente informativo e não devem ser, em nenhuma circunstância, considerados como substitutos de aconselhamento médico.